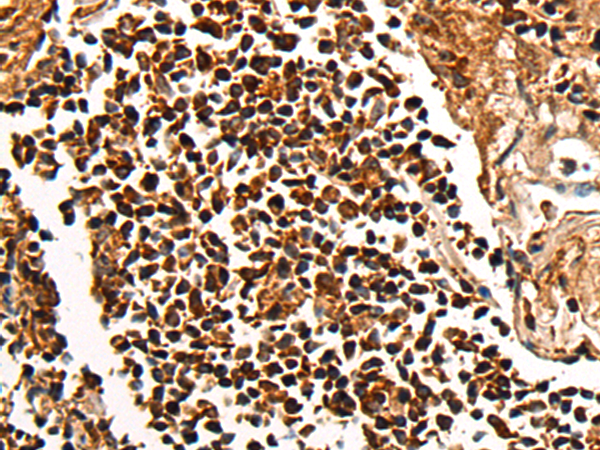
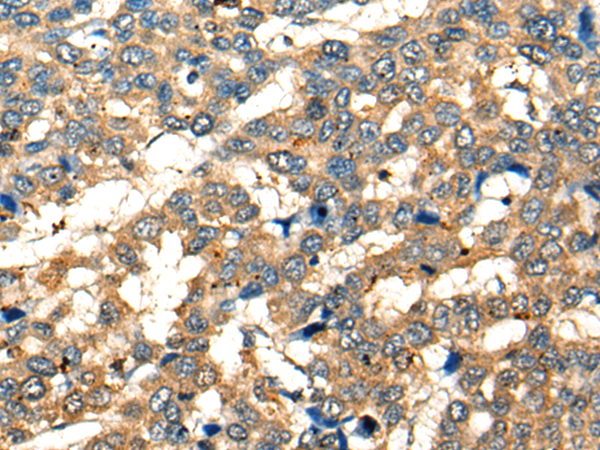
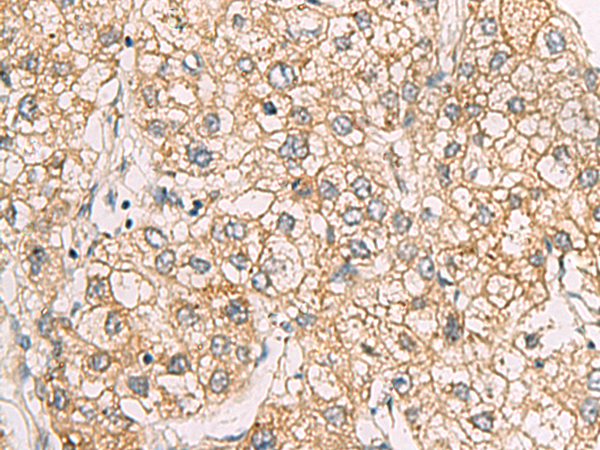

-
分类: 科研抗体货号: P13045别名: cdc14; hCDC14; DFNB105应用: IHC反应种属: Human, Mouse
-
分类: 科研抗体货号: P13064别名: CRAG; AGAP-3; CENTG3; MRIP-1; cnt-g3应用: IHC反应种属: Human, Mouse
-
分类: 科研抗体货号: P13083别名: C2TA; NLRA; MHC2TA; CIITAIV应用: IHC反应种属: Human, Mouse
-
分类: 科研抗体货号: P13044别名: CD64; FCRI; CD64A; IGFR1应用: IHC反应种属: Human
-
分类: 科研抗体货号: P13063别名: CENP-T; C16orf56应用: IHC反应种属: Human, Mouse, Rat
-
分类: 科研抗体货号: P13082别名: chch; My015; C14orf52应用: IHC反应种属: Human, Mouse
-
分类: 科研抗体货号: P13040别名: Tp44应用: IHC反应种属: Human
-
分类: 科研抗体货号: P13061别名: BM88应用: WB,IHC反应种属: Human, Mouse, Rat
-
分类: 科研抗体货号: P13080别名: C6ST; GST2; GST-2; Gn6ST-1; HEL-S-75; glcNAc6ST-1应用: WB,IHC反应种属: Human, Mouse
-
分类: 科研抗体货号: P13060别名: NECL3; IGSF4D; Necl-3; synCAM2; SynCAM 2应用: WB,IHC反应种属: Human, Mouse, Rat

鄂公网安备42018502007531号
鄂公网安备42018502007531号

